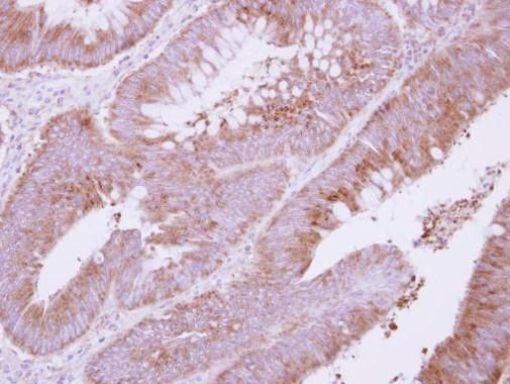
ADAMTS1 Antibody in Immunohistochemistry (Paraffin) (IHC (P))

Search
Invitrogen
ADAMTS1 Polyclonal Antibody
{{$productOrderCtrl.translations['antibody.pdp.commerceCard.promotion.promotions']}}
{{$productOrderCtrl.translations['antibody.pdp.commerceCard.promotion.viewpromo']}}
{{$productOrderCtrl.translations['antibody.pdp.commerceCard.promotion.promocode']}}: {{promo.promoCode}} {{promo.promoTitle}} {{promo.promoDescription}}. {{$productOrderCtrl.translations['antibody.pdp.commerceCard.promotion.learnmore']}}
产品信息
PA5-29864
宿主/亚型
分类
类型
抗原
偶联物
形式
浓度
保存条件
运输条件
RRID
产品详细信息
PA5-29864 targets ADAMTS1 in IHC (P) and WB applications and shows reactivity with Human samples.
The PA5-29864 immunogen is recombinant fragment corresponding to a region within amino acids 318 and 643 of Human ADAMTS1.
靶标信息
ADAMTS-1 is a member of the ADAMTS (a disintegrin and metalloproteinase with thrombospondin motif) protein family. Members of the family share several distinct protein modules, including a propeptide region, a metalloproteinase domain, a disintegrin-like domain, and a thrombospondin type 1 (TS) motif. Individual members of this family differ in the number of C-terminal TS motifs, and some have unique C-terminal domains. The protein encoded by this gene contains two disintegrin loops and three C-terminal TS motifs and has anti-angiogenic activity. The expression of this gene may be associated with various inflammatory processes as well as development of cancer cachexia. This gene is likely to be necessary for normal growth, fertility, and organ morphology and function.
⚠WARNING: This product can expose you to chemicals including mercury, which is known to the State of California to cause birth defects or other reproductive harm. For more information go to www.P65Warnings.ca.gov.
仅用于科研。不用于诊断过程。未经明确授权不得转售。